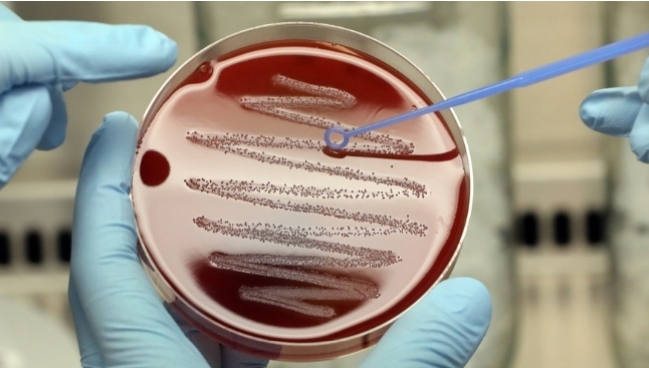

Un nuevo informe de los Centros para el Control y la Prevención de Enfermedades de Estados Unidos (CDC, por sus siglas en inglés) advierte que China podría estar detrás del aumento mundial de una nueva enfermedad infecciosa: la supergonorrea.
Según el reporte, publicado esta semana, alrededor del 98 % de las muestras de bacterias tomadas en pacientes con la Enfermedad de Transmisión Sexual en 13 provincias chinas eran capaces de eludir exitosamente uno de los antibióticos de primera línea.
De las más de 2.800 muestras de bacterias de pacientes con gonorrea en China que se recogieron en 2022, cerca del 98 % resultaron resistentes al fármaco ciprofloxacino, mientras que cerca del 78 % resistió el tratamiento con penicilina. Asimismo, alrededor del 17 % de las muestras demostraron ser resistentes a la azitromicina y a la cefixima, mientras que un 8 % resultaron inmunes a la ceftriaxona, un porcentaje muy superior al registrado por otros países.
Los casos de supergonorrea resistente a los antibióticos no son nuevos. Sin embargo, China registra tasas 40 veces superiores a las de otros países, como Estados Unidos, Reino Unido y Canadá, lo que preocupa a los médicos.
Por ejemplo, en 2022 en Reino Unido solo un 0,2 % de las muestras mostraron susceptibilidad reducida a la ceftriaxioma, la misma cifra que registró Estados Unidos entre los años 2016 y 2020. Mientras tanto, en Canadá la resistencia a este mismo antibiótico fue alrededor de 0,6 % entre 2017 y 2021.